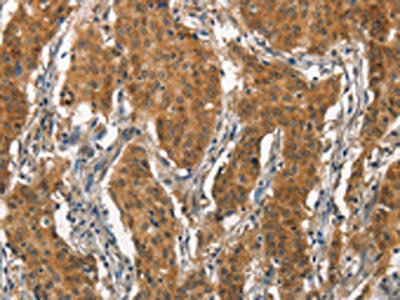

ITGA2 Antibody
-
中文名稱:ITGA2兔多克隆抗體
-
貨號:CSB-PA938467
-
規(guī)格:¥1100
-
圖片:
-
The image on the left is immunohistochemistry of paraffin-embedded Human gastic cancer tissue using CSB-PA938467(ITGA2 Antibody) at dilution 1/15, on the right is treated with synthetic peptide. (Original magnification: ×200)
-
The image on the left is immunohistochemistry of paraffin-embedded Human thyroid cancer tissue using CSB-PA938467(ITGA2 Antibody) at dilution 1/15, on the right is treated with synthetic peptide. (Original magnification: ×200)
-
Gel: 6%SDS-PAGE, Lysate: 40 μg, Lane 1-2: Human lung cancer tissue, A431 cells, Primary antibody: CSB-PA938467(ITGA2 Antibody) at dilution 1/300, Secondary antibody: Goat anti rabbit IgG at 1/8000 dilution, Exposure time: 40 seconds
-
-
其他:
產(chǎn)品詳情
-
Uniprot No.:
-
基因名:
-
別名:BR antibody; CD 49b antibody; CD49 antigen like family member B antibody; CD49 antigen-like family member B antibody; CD49b antibody; CD49b antigen antibody; Collagen receptor antibody; DX5 antibody; Glycoprotein Ia deficiency included antibody; GP Ia antibody; GP Ia deficiency; included antibody; GPIa antibody; HPA 5 included antibody; HPA5 included antibody; Human platelet alloantigen system 5 antibody; Integrin alpha 2 antibody; Integrin alpha II antibody; Integrin alpha-2 antibody; Integrin; alpha 2 (CD49B alpha 2 subunit of VLA 2 receptor) antibody; ITA2_HUMAN antibody; ITGA2 antibody; Platelet alloantigen Br(a); included antibody; Platelet antigen Br antibody; Platelet glycoprotein GPIa antibody; Platelet glycoprotein Ia antibody; Platelet glycoprotein Ia/IIa antibody; Platelet membrane glycoprotein Ia antibody; Platelet receptor for collagen; deficiency of; included antibody; Very late activation protein 2 receptor alpha 2 subunit antibody; VLA 2 alpha chain antibody; VLA 2 antibody; VLA 2 subunit alpha antibody; VLA-2 subunit alpha antibody; VLA2 antibody; VLA2 receptor alpha 2 subunit antibody; VLAA2 antibody
-
宿主:Rabbit
-
反應(yīng)種屬:Human
-
免疫原:Synthetic peptide of Human ITGA2
-
免疫原種屬:Homo sapiens (Human)
-
標(biāo)記方式:Non-conjugated
-
抗體亞型:IgG
-
純化方式:Antigen affinity purification
-
濃度:It differs from different batches. Please contact us to confirm it.
-
保存緩沖液:-20°C, pH7.4 PBS, 0.05% NaN3, 40% Glycerol
-
產(chǎn)品提供形式:Liquid
-
應(yīng)用范圍:ELISA,WB,IHC
-
推薦稀釋比:
Application Recommended Dilution ELISA 1:2000-1:5000 WB 1:500-1:2000 IHC 1:25-1:100 -
Protocols:
-
儲存條件:Upon receipt, store at -20°C or -80°C. Avoid repeated freeze.
-
貨期:Basically, we can dispatch the products out in 1-3 working days after receiving your orders. Delivery time maybe differs from different purchasing way or location, please kindly consult your local distributors for specific delivery time.
-
用途:For Research Use Only. Not for use in diagnostic or therapeutic procedures.
相關(guān)產(chǎn)品
靶點(diǎn)詳情
-
功能:Integrin alpha-2/beta-1 is a receptor for laminin, collagen, collagen C-propeptides, fibronectin and E-cadherin. It recognizes the proline-hydroxylated sequence G-F-P-G-E-R in collagen. It is responsible for adhesion of platelets and other cells to collagens, modulation of collagen and collagenase gene expression, force generation and organization of newly synthesized extracellular matrix.; (Microbial infection) Integrin ITGA2:ITGB1 acts as a receptor for Human rotavirus A.; (Microbial infection) Integrin ITGA2:ITGB1 acts as a receptor for Human echoviruses 1 and 8.
-
基因功能參考文獻(xiàn):
- Interleukin-4 induces a CD44high /CD49bhigh PC3 subpopulation with tumor-initiating characteristics PMID: 29236307
- Carriage of a combination of mutant alleles in multiple genes including ITGB3+CYP2C19*2 or CYP2C19*2 + ITGA2 or CYP2C19*2 are possible predictors of CVE in patients after CABG PMID: 29461866
- Studied the association between integrin subunit alpha 2 (GPIa) and prostaglandin-endoperoxide synthase 2 (COX-2) genetic polymorphisms in Chinese ishemic stroke patients with or without aspirin resistance. PMID: 28948649
- GP Ia C807T polymorphism may contribute to ischemic stroke development in the Chinese population (meta-analysis). PMID: 29208186
- The authors identified a cell surface marker, ITGA2, which marks a proliferative trophoblast progenitor compartment in the first trimester placenta that is regulated by NOTCH signalling and exhibits unique expression characteristics. PMID: 29540503
- discovered that OLFM4, CD11b, and ITGA2 are proteins that are overexpressed in both primary colon tumors and liver metastasis. These are colon cancer biomarkers with autoantigenic properties. PMID: 28669815
- This study demonstrated that the transactivation of FOXL2 driven by interactions between HMGA2 and pRb might exert critical effects on the metastases and EMT of chemoresistant gastric cancer. Blocking the HMGA2-FOXL2-ITGA2 pathway could serve as a new strategy for gastric cancer treatment. PMID: 28119367
- The GpIa-C807T and GpIIIa-PlA1/PlA2 polymorphisms and more pronouncedly their combination are associated with increased risk of spontaneous abortions. PMID: 27405521
- The allele combination of CGC from hOGG1, ITGA2 and XPD polymorphisms was significantly associated with increased odds of nasopharyngeal carcinoma. PMID: 29121049
- blood platelets have a role in amyloid-beta aggregation in cerebral vessels through integrin alphaIIbbeta3-induced outside-in signaling and clusterin release PMID: 27221710
- Exposure to magnesium ions facilitated hBMSC proliferation via integrin alpha2 and alpha3 expression and partly promoted differentiation into osteoblasts via the alteration of ALP expression and activity PMID: 24616281
- The synonymous common variant, GPIA rs1126643, increases the long-term adverse events risk of CABG by augmenting GPIa protein expression and enhancing platelet aggregation function. PMID: 27881421
- we found a significant cumulative contribution of the genetic heterogeneity of glycoproteins Ia and IIIa and platelet-endothelial cell adhesion molecule-1 and P-Selectin genes in the risk of recurrent IVF-ET failures. The coexistence of these SNPs was associated with increased IVF-ET failure risk and the more polymorphic alleles or genotypes were present the higher the risk of IVF-ET failure, especially for younger women PMID: 28388872
- Meta-analysis found that glycoprotein Ia C807T T allele or the TT genotype, the Ser-allele of HPA-3 and B allele of glycoprotein Ibalpha variable number tandem repeat polymorphisms were associated with increased risk for ischemic stroke. PMID: 28004990
- Data indicate no association of maternal or fetal ITGA2 C807T SNP, ITGB3 T1565C SNP, PECAM1 CTG - GTG and SELP A/C polymorphisms with fetal growth restriction (FGR). PMID: 28358707
- The most common HPA genotypes among Saudis were HPA-1 a + b- (75%), HPA-2 a + b- (62%), HPA-3 a + b- (51.5%), HPA-4 a + b- (99%), HPA-5 a + b- (76.5%), HPA-6 a + b- (100%) and HPA-15 a + b + (50%). The prevalent allele among the HPA systems was (a), except in the HPA-15 system where the (b) allele was found in 52% of the subjects. PMID: 27019315
- A sulfonamide-type small-molecule inhibitor of alpha2beta1 integrin decreased average platelet adhesion in individuals with the C/T807T genotype but not in those harboring C807C. PMID: 26556301
- Platelet GP Ia 807C/T polymorphism could be a protective factor of for cerebral hemorrhage in the Chinese population. PMID: 26134877
- high miR-128 expression suppressed osteosarcoma cell migration, invasion, and EMT development through targeting ITGA2, which may be recommended as a therapeutic target for osteosarcoma. PMID: 26700675
- Study identified a novel RANKL function in the promotion of cell adhesion to type I collagen through the RANKL-NF-kappa B-integrin alpha 2 pathway and found integrin alpha2 and RANKL up-regulated in non small cell lung carcinoma. PMID: 27009236
- Recently, new clinical observations of genetic diseases provided evidence bringing new data on the role of alphaIIbbeta3 integrin in defective megakaryopoiesis. [review] PMID: 27011248
- High ITGA2 expression is associated with cervical cancer. PMID: 26758421
- PDI-mediated disulfide bond exchange plays a pivotal role in the post-ligation phase of alphaIIbbeta3-mediated adhesion to fibrinogen, while this step in alphavbeta3-mediated adhesion is independent of disulfide exchange PMID: 26514956
- Our results indicate that GpIa-807T and GpIIIa-PlA2 may be susceptibility alleles for in vitro fertilization implantation failure. PMID: 25643034
- PFL-mediated downregulation of integrin and EGFR contributes to the inhibition of tumor growth in vitro and in vivo. This novel anti-cancer mechanism of PFL suggests that this lectin would be useful as an anti-cancer drug or an adjuvant for other drugs. PMID: 26850110
- HRG binds to alpha2 integrin through low-affinity interactions in a heparin sulfate-independent manner, thereby blocking endothelial cells adhesion to collagen I. PMID: 26051322
- The Glycoprotein Ia C807T polymorphism might be a risk factor for the development and relapse of Acute Coronary Syndrome PMID: 26304618
- Data indicate that in recurrent spontaneous abortion patients, the expression levels of CD49b and LAG-3 (CD223) on CD14(+) mononuclear cells and the plasma level of transforming growth factor beta (TGF-beta) decreased obviously compared with normal females. PMID: 26927558
- Integrin alpha 2 and alpha 4 Yxxphi motifs interact with the endocytic clathrin adaptor, AP2 complex. PMID: 26779610
- Epigenetic silencing of ITGA2 by MiR-373 promotes cell migration in breast cancer. PMID: 26258411
- A highly bone metastatic RANKL-overexpressing prostate cancer cell line, LNCaP(RANKL)used as a model to study increased adhesion of prostate cancer (PCa) cells to collagens and found 3-D suspension culture and in vivo PCa tumor growth restore AR through downregulation of AP-4, enhancing integrin alpha2 expression and adhesion to ColI which is rich in bone matrices. PMID: 25200184
- diabetic retinopathy is associated with ITGA2 and ITGB3 PlA1/A2 polymorphisms (Meta-Analysis) PMID: 24979111
- This study shows that osteoblastic differentiation is improved on 3D scaffolds with submicron-scale texture and is mediated by integrin alpha2beta1. PMID: 25203434
- Current review discusses the mechanisms by which integrin is activated and subsequently deactivated by focusing on its structure-function relationship PMID: 26152212
- Polymorphism of HPA- 5 is probably a risk factor for carotid atherosclerosis complicating T2DM. PMID: 25966234
- blockade of alpha2beta1 integrin with a neutralizing mAb inhibited IL-7-induced bone loss and osteoclast numbers by reducing Th17 cell numbers in the bone marrow PMID: 26408663
- EZH2-silenced cells the signaling activity of the de-repressed ITGalpha2 is able to increase cofilin phosphorylation, which in turn reduces cell migration. PMID: 25549357
- The Integrin alpha2 2 gene C807T polymorphism may be a susceptible predictor of the risk of ischemic stroke. PMID: 24397542
- CD34 and CD49b are cell surface markers that can be used to enrich a subpopulation of leiomyoma cells possessing stem/progenitor cell properties. PMID: 25658015
- alpha2beta1 integrin gene expression levels were increased significantly in keloid fibroblasts under tension compared to normal fibroblasts under tension. Knockdown of Integrin A2B1 reduced cell proliferation in fibroblasts under tension. PMID: 25046655
- Carbohydrate-to-carbohydrate interactions between alpha2,3-linked sialic acids on alpha2 integrin subunits and asialo-GM1 underlie the bone metastatic behaviour of LNCAP-derivative C4-2B prostate cancer cells. PMID: 25137483
- The alphaII b tail sequences distal of GFFKR participate in talin-mediated inside-out alphaII b beta3 activation through its steric clashes with beta3 -bound talin PMID: 24837519
- The alpha2beta1 integrin mediates T-acute lymphoblastic leukemia cell migration through collagen in ERK and p38 MAPKs-dependent manner PMID: 24880062
- These results reveal betaig-h3 enhances the metastasis potentials of human osteosarcoma cells via integrin alpha2beta1-mediated PI3K/AKT signal pathways. PMID: 24595049
- ITGA2 is downregulated 39-fold by silencing of laeverin in trophoblasts, reducing cell migration and invasion. PMID: 24959655
- Molecular modeling indicated that galactosylation occurred on the periphery of alpha2beta1 integrin interaction with alpha1(IV)382-393 but right in the middle of alpha3beta1 integrin interaction with alpha1(IV)531-543 PMID: 24958723
- ITGA2 +807 gene polymorphism is not associated with susceptibility to CsA-induced GO. PMID: 24581850
- glycoprotein Ia C807T polymorphism is associated with idiopathic sudden hearing loss. PMID: 24466284
- It plays a role in regulation of leukocyte migration to a site of inflammation. PMID: 24850451
- Usage of internal N-acetylneuraminic acids and alpha2beta1 integrin by Wa rotavirus was at least partially additive. PMID: 24501414
顯示更多
收起更多
-
亞細(xì)胞定位:Membrane; Single-pass type I membrane protein.
-
蛋白家族:Integrin alpha chain family
-
數(shù)據(jù)庫鏈接:
Most popular with customers
-
-
YWHAB Recombinant Monoclonal Antibody
Applications: ELISA, WB, IHC, IF, FC
Species Reactivity: Human, Mouse, Rat
-
Phospho-YAP1 (S127) Recombinant Monoclonal Antibody
Applications: ELISA, WB, IHC
Species Reactivity: Human
-
-
-
-
-